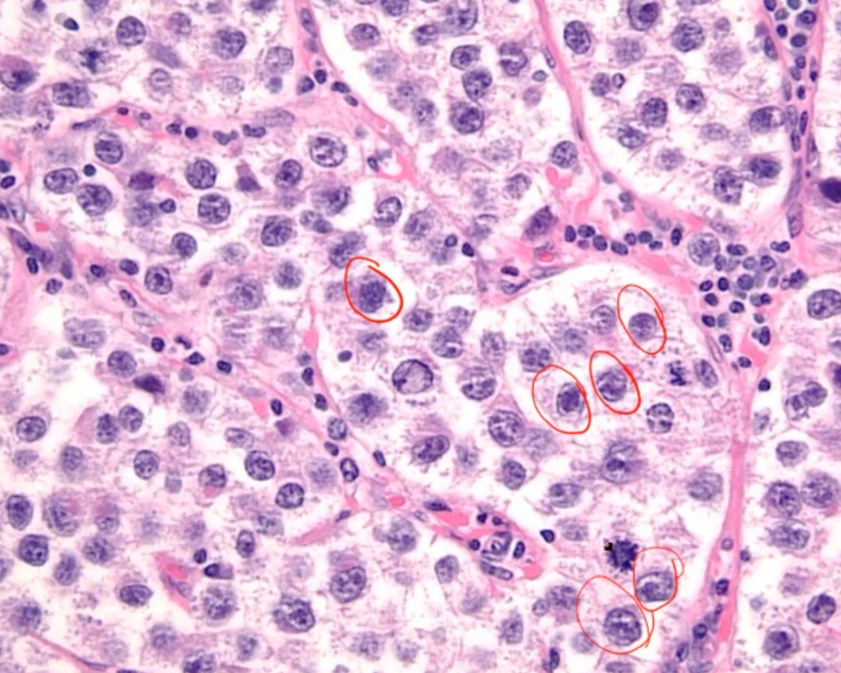

Neoplastic Ovarian Pathology
Ovarian Tumors
_Ovary is composed of surface epithelium, germ cells (egg), sex cord stroma (theca and granulosa)..

15-30: Germ cell tumors
35-40 benign surface
60-70 malignant..
Surface Epithelial Tumors
_Most common type of ovarian tumor. They comprise approximately 70% of all ovarian neoplasms, and 80-90% of all malignant ovarian neoplasms.,
_In general, they carry a poor prognosis.The malignant types of surface epithelial tumors have a tendency to seed the peritoneal cavity. (Spread locally).,

_Derived from coelomic epithelium (aka surface epithelium) that lines the ovary; coelomic epithelium embryologically produces the epithelium lining of the fallopian tube (serous cells), endometrium, and endocervix (mucinous cells).,
_The two most common subtypes of surface epithelial tumors are serous (full of watery fluid) and mucinous (full of mucus-like fluid); both are usually cystic.
Less common subtypes of surface epithelial tumors include endometrioid and Brenner tumor..
_Mucinous and serous tumors can be classified into one of the following three types:
Benign (cystadenomas): composed of a single cyst with a simple, flat lining; most commonly arise in premenopausal women (30-40 years old). Cyst: cystic. Adeno: glandular. Oma: benign
Malignant (cystadenocarcinomas): composed of complex cysts with a thick, shaggy lining; most commonly arise in postmenopausal women (60-70 years old)(invade)
Borderline: contain features in between benign and malignant tumors; carry a better prognosis than clearly malignant tumors, but still carry metastatic potential..
_Major risk factors:
Genetic: BRCA1 mutation, Lynch syndrome (HNPCC) (BRCA increases fallopian tube and ovary serous carcinoma. Carriers often elect to have prophylactic salpingo oophorectomy and mastectomy)
The risk is decreased with a history of breastfeeding, OCPs, and pregnancy.,
_Clinically, the tumor marker that can be used to monitor is serum CA-125.,
Serous tumor
_Serous Tumors of the ovary are derived from coelomic epithelium, and in the case of the serous tumors, they differentiate into tubal epithelium. Approximately 60% are benign, and roughly 15% are considered borderline malignancy. These occur most commonly in women of reproductive age. The malignant tumors comprise 25% of cases and tend to occur in older patients..
_The most common benign and malignant types of ovarian tumors overall.,
_Are often bilateral, and this is particularly true for the malignant subtypes..
_Histology will appear as lined ciliated cells with fallopian tube-like epithelium.
Malignant type will reveal psammoma bodies(dystrophic calcification), and demonstrate invasive papillary histology.,
Serous cystadenoma of the ovary. On microscopic examination, the cyst is lined by a single layer of ciliated tubal-type epithelium.

Serous cystadenocarcinoma. A higher-power view shows the laminated structure of a psammoma body.

Mucinous Tumors
_ Are derived from coelomic epithelium, they differentiate into mucus-secreting epithelium that resembles the endocervix. They represent approximately 20% of all ovarian tumors, and 10% of all malignant ovarian tumors..
_ Most commonly unilateral (whereas serous tumors are commonly bilateral), solid, rarely calcify to form psammoma bodies, and are often large (>10 cm) cystic tumors..
_ Mucinous cystadenoma histology will reveal multilocular cysts lined by endocervical-like mucus-secreting epithelial cells..

_Mucinous cystadenocarcinoma of the ovary commonly rupture to produce pseudomyxoma peritonei, which is an intraperitoneal accumulation of mucinous material from ovarian or appendiceal tumor (mucinous ascites). However, pseudomyxoma peritonei is most often caused by a tumor of the appendix, not the ovaries..

Endometrioid Tumor
_A less common subtype of surface epithelial tumor; composed of endometrial-like glands and are usually malignant..
_ commonly occur in setting of endometriosis (ectopic endometrial tissue) within the ovary with cyst formation. Approximately 15% of endometrioid carcinomas of the ovary are associated with an independent endometrial carcinoma (endometrioid type, urothelium). When endometriosis occurs within the ovary it commonly results in the formation of a "Chocolate Cyst," which is an endometrioma filled with dark, reddish-brown blood..
_Clinically present with pelvic pain, dysmenorrhea, dyspareunia; symptoms commonly vary with the menstrual cycle. A complex mass will often be observed on ultrasound. Possess histopathological features similar to endometrial cancer of the uterus..
Brenner Tumor
_A less common subtype of surface epithelial ovarian tumors. The majority are benign, but some can be malignant..
_Appear as a solid tumor that is pale yellow-tan and appears encapsulated
Histology will often reveal "Coffee bean" nuclei with H&E staining. They are also characterized by Walthard’s rests, which are islands of bladder-like transitional epithelium within a fibrous stroma.,
Brenner tumor on H&E stain. These tumours are thought to arise from Walthard cell rests. They exhibit characteristic coffee bean nuclei (clearly visible in image). On low magnification, they resemble urothelial cell nests.

Brenner tumor displaying the characteristic "coffee bean" nuclei

Germ Cell Tumors
_Second most common type of ovarian tumor (approximately 15% of cases), and they usually only occur in women of reproductive age.(15-30).,
_Can mimic tissues that are normally produced by germ cells, and we can use microscopy to make a diagnosis based on the tissue produced:
Fetal Tissue: cystic teratoma (tumor with different embryo layers), embryonal carcinoma (primitive cells)
Oocytes: dysgerminoma
Yolk Sac: endodermal sinus tumor
Placental Tissue: choriocarcinoma.,
Dysgerminoma
_ Tumor composed of large cells with clear cytoplasm and central nuclei (resemble oocytes)., Dys: bad. Germ: germ cell.
Dysgerminoma. The neoplastic germ cells have clear, glycogen-filled cytoplasm and central nuclei. Fibrous septa containing lymphocytes traverse the tumor.
_Most common malignant germ cell tumor in females.,
Seminoma
_Testicular counterpart to the dysgerminoma, which is a relatively common germ cell tumor in males.,
_ Diagnosed by histology, and the measurement of the following tumor markers can also be used to confirm the diagnosis:
Increased levels of hCG
Increased levels of LDH.,
_Patients with streak gonads, such as those seen in Turner Syndrome, have an increased risk.. As a result, patients with Turner Syndrome often have their ovaries prophylactically removed.
_ carry a good prognosis, and they respond very well to radiation..
Teratomas
_Tumors that are comprised of tissue elements derived from two or three embryonic layers:
Endoderm (e.g. bronchial, thyroid tissue)
Mesoderm (e.g. cartilage, bone)
Ectoderm (e.g. hair, skin, neural tissue).,

_(Dermoid cyst) is a cystic tumor composed of fetal tissue derived from two or three embryologic layers. They are the most common benign ovarian germ cell tumor in women 20-30 years old.
Bilateral in 10% of cases..
_Commonly presents with pain that is secondary to ovarian enlargement or torsion.,
_Benign, but presence of immature tissue (usually neural) or somatic malignancy (usually squamous cell carcinoma of the skin) indicates malignant potential..
Struma ovarii
_aka monodermal teratoma, is a rare form of monodermal teratoma that is mostly comprised of thyroid tissue, and often leads to symptoms of hyperthyroidism. They are usually unilateral, and most commonly seen in mature teratomas.,

_Immature Teratomas are rare, aggressive and malignant ovarian germ cell tumors (usually squamous). They are
Tissues in teratoma with cancer
often contain neuroectoderm (immature tissue) and are most commonly diagnosed in young women.
somatic malignancy (sqamous cell carcinoma of skin)..
Yolk Sac Tumor
_Aka Endodermal sinus tumor.,
_Will commonly arise in any of the following three locations:
Ovaries (females)
Testes (males)
Sacrococcygeal area (males, females).,
_5 year old girl with ovarian mass.,
_Most common germ cell tumor in children.,
_Histology classically reveal Schiller-Duval bodies which are glomerulus-like structures (pathognomonic finding). Grossly, these tumors appear as a yellow, friable (hemorrhagic), solid mass.,

_ classically have an elevated AFP.,
Embryonal Carcinoma
_Rare, malignant tumor composed of large primitive cells. The median age of diagnosis is 15 years. They are aggressive with early metastasis (may present with back pain)(embryonal cells likes to move and spread), and are often associated with hemorrhage and necrosis. There may be serum elevations of hCG and AFP.,

Choriocarcinoma
_Malignant tumor composed of cytotrophoblasts and syncytiotrophoblasts.,

_Mimics placental tissue, but villi are absent..
_Small, hemorrhagic tumor with early hematogenous spread (Genetically programmed to invade bv)..
_High beta-hcg is characteristic(produced by syncytiotrophoblasts)..
_May lead to thecae-lutein cysts in the ovary. Poor prognosis to chemo.,
Sex-Cord Stromal Tumors
_Tumors resemble sex cord tissues of ovary..
Fibroma
_A benign, solid tumor consisting of bundles of spindle-shaped fibroblasts.,
Bundles of spindle-shaped fibroblasts.
White bands: fibrosis 
_Are classically associated with Meigs syndrome., which consists of the following triad of findings:
Ovarian fibroma
Ascites
Pleural effusion (commonly on the right side)
A common symptom in patients with Meigs syndrome is the complaint of a pulling sensation in the groin. The syndrome will resolve with removal of the tumor.
Granulose-Cell Tumor
_A neoplastic proliferation of granulosa cells, and it is the most common malignant stromal tumor (commonly seen in women in their 50s)..
_ are estrogen-secreting tumors, and patients will present with signs of estrogen excess. The clinical presentation of hyperestrinism varies by the age of the patient:
Prior to puberty: precocious (early) puberty
Reproductive age: menorrhagia or metrorrhagia
Postmenopause (most common): endometrial hyperplasia with vaginal/uterine bleeding.,
In postmenopausal women granulosa cell tumors are highly associated with endometrial hyperplasia and the development of endometrial carcinoma. Although these are malignant tumors, they often carry a minimal risk for metastasis.
_Histology reveal cells with scanty cytoplasm and angulated, coffee-bean, grooved nuclei. The classic features are Call-Exner bodies., which are granulosa cells arranged in small follicles filled with eosinophilic secretions in the center.
Granulosa cell tumor: showing diffuse proliferation of small round cells.

Call-Exner Bodies seen in granulosa cell tumor

Thecoma
_A benign tumor of theca cells that are typically estrogen-producing. They most commonly occur in post-menopausal women, and usually present with abnormal uterine bleeding. Similar to granulose cell tumor.,
_Histology will reveal cells with abundant lipid-filled cytoplasm. Grossly these are solid, yellow appearing tumors.,
Thecoma of the ovary:


Sertoli-Leydig Cell Tumor
_Composed of Sertoli cells that form tubules and Leydig cells with characteristic Reinke crystals (Pink cells with crystals). These tumors have the ability to produce androgen, which is associated with the development of hirsutism and virilization.,


Note: although these tumors most commonly occur in males, they can also develop in females because they are derived from sex-cord stromal tissue.
Metastasis
_Metastasis to the ovary comprise roughly 5% of all cases of ovarian tumors, and they will most frequently originate from primaries found in the:
Gastrointestinal tract (i.e. Gastric Carcinoma - Diffuse type)
Breast
Uterus
Appendix (pseudomyxoma peritonei)..
Krukenberg Tumor
_Metastatic mucinous tumor that involves both ovaries, and is most commonly due to a metastatic gastric carcinoma (diffuse type)..
_Bilaterality helps distinguish a metastasis from a primary mucinous carcinoma of the ovary, which is usually unilateral..
_The most common route of metastasis is hematogenous..
_Histology of the tumors will reveal signet ring cells and mucin-secreting cells.,

Pseudomyxoma peritonei
_Condition that is characterized by massive amounts of mucus in the peritoneum (jelly belly). It is most commonly caused by a mucinous tumor of the appendix, usually with metastasis to the ovary. (primary tumor in appendix, mucous in peritoneum, mets to ovary).,
Pseudomyxoma peritonei with massive amounts of mucus in the peritoneum (arrows) 
Last updated